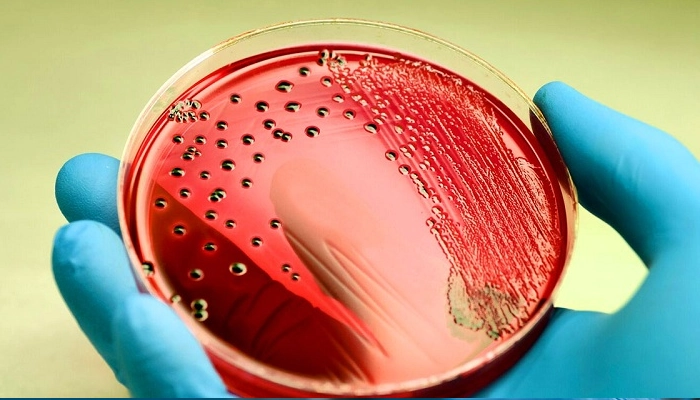

Nhiễm Trùng Máu Là Gì? Có Nguy Hiểm Không? Dấu Hiệu Và Cách Xử Lý
Tóm Tắt Nhanh
-
Nhiễm trùng máu là gì? Phản ứng viêm toàn thân nguy hiểm khi hệ miễn dịch phản ứng thái quá với nhiễm trùng, gây tổn thương các cơ quan
-
Tên y khoa: Sepsis (nhiễm khuẩn huyết / hội chứng nhiễm khuẩn toàn thân)
-
Có nguy hiểm không? Rất nguy hiểm — tỷ lệ tử vong toàn cầu 15–30%, lên đến 40–50% với sốc nhiễm khuẩn
-
Dấu hiệu cảnh báo sớm: Sốt cao hoặc hạ thân nhiệt đột ngột, tim đập nhanh, thở nhanh, lú lẫn, da mốc xanh
-
Điều trị: Cấp cứu khẩn cấp — kháng sinh tĩnh mạch, bù dịch, hỗ trợ cơ quan tại ICU
-
Thời gian vàng: Mỗi giờ trì hoãn điều trị tăng nguy cơ tử vong thêm 7%
Nhiễm trùng máu là gì? Có nguy hiểm không?
1. Nhiễm Trùng Máu Là Gì?
Nhiễm trùng máu — tên y khoa là sepsis (nhiễm khuẩn huyết) — không đơn giản là vi khuẩn "vào máu" như nhiều người vẫn hiểu nhầm. Đây là một hội chứng lâm sàng phức tạp hơn nhiều.
Theo định nghĩa của Sepsis-3 (2016) — tiêu chuẩn quốc tế được WHO và CDC áp dụng — Nhiễm trùng máu là phản ứng rối loạn điều hoà của cơ thể đối với nhiễm trùng, dẫn đến rối loạn chức năng cơ quan đe doạ tính mạng.
Nói đơn giản hơn: khi cơ thể bị nhiễm trùng (vi khuẩn, virus, nấm), hệ thống miễn dịch phóng thích một lượng lớn cytokine và các chất trung gian viêm để chống lại mầm bệnh. Trong nhiễm khuẩn huyết, phản ứng viêm này vượt tầm kiểm soát, tấn công ngược lại chính các mô và cơ quan của cơ thể — tim, phổi, thận, gan, não — gây ra suy đa tạng và tử vong nếu không được can thiệp kịp thời.
Phân Biệt 3 Mức Độ Từ Nhẹ Đến Nặng
-
Sepsis (Nhiễm khuẩn huyết): Nhiễm trùng kèm rối loạn chức năng cơ quan — điểm SOFA ≥ 2
-
Severe Sepsis (Nhiễm khuẩn huyết nặng): Nhiễm khuẩn máu kèm suy ít nhất một cơ quan (thận, gan, phổi, não…)
-
Septic Shock (Sốc nhiễm khuẩn): Mức độ nặng nhất — tụt huyết áp không đáp ứng với bù dịch, cần thuốc vận mạch để duy trì huyết áp trung bình ≥ 65 mmHg. Tỷ lệ tử vong lên đến 40–50%.
2. Nhiễm Trùng Máu Có Nguy Hiểm Không?
Cực kỳ nguy hiểm — đây là một trong những nguyên nhân tử vong hàng đầu tại các bệnh viện trên toàn thế giới.
Theo số liệu của WHO và The Lancet (2020):
-
Mỗi năm có khoảng 48,9 triệu ca nhiễm trùng máu trên toàn cầu
-
Khoảng 11 triệu người tử vong do nhiễm trùng máu mỗi năm — chiếm gần 20% tổng số ca tử vong toàn cầu
-
Tại Việt Nam, nhiễm trùng máu là nguyên nhân hàng đầu gây tử vong tại các khoa Hồi sức tích cực (ICU)
-
Mỗi giờ trì hoãn điều trị kháng sinh tăng nguy cơ tử vong thêm 7% (theo nghiên cứu đăng trên Critical Care Medicine)
Điều khiến nhiễm trùng huyết đặc biệt nguy hiểm không chỉ là tỷ lệ tử vong cao — mà còn là tốc độ tiến triển. Bệnh có thể chuyển từ giai đoạn đầu sang sốc nhiễm khuẩn trong vài giờ, khiến người thân không kịp nhận ra và đưa bệnh nhân đến viện.
Nhiễm trùng máu là một biến chứng y khoa nguy hiểm, cần được điều trị kịp thời tại bệnh viện.
3. Nguyên Nhân Nhiễm Trùng Máu
Vậy lý do tại sao bị nhiễm trùng máu? Nhiễm trùng máu có thể xuất phát từ bất kỳ ổ nhiễm trùng nào trong cơ thể. Các nguyên nhân phổ biến nhất:
-
Nhiễm trùng phổi (viêm phổi): Chiếm khoảng 30–40% ca sepsis — nguyên nhân hàng đầu
-
Nhiễm trùng đường tiểu (UTI): Phổ biến ở phụ nữ và người cao tuổi — vi khuẩn từ đường tiểu xâm nhập vào máu qua thận
-
Nhiễm trùng ổ bụng: Viêm ruột thừa vỡ, viêm phúc mạc, áp xe gan — vi khuẩn gram âm từ đường tiêu hoá
-
Nhiễm trùng da và mô mềm: Vết thương hở, bỏng nặng, cellulitis (viêm mô tế bào) — đặc biệt nguy hiểm với người tiểu đường
-
Nhiễm trùng liên quan đến dụng cụ y tế: Catheter tĩnh mạch trung tâm, ống thở máy, dụng cụ tiết niệu — sepsis bệnh viện (nosocomial sepsis)
Vi sinh vật gây bệnh phổ biến:
-
Vi khuẩn gram âm: Escherichia coli, Klebsiella pneumoniae, Pseudomonas aeruginosa
-
Vi khuẩn gram dương: Staphylococcus aureus (bao gồm MRSA), Streptococcus pneumoniae
-
Nấm: Candida spp. — thường gặp ở bệnh nhân suy giảm miễn dịch
4. Dấu Hiệu Nhận Biết Nhiễm Trùng Máu Sớm
Đây là phần rất quan trọng: nhận biết sớm dấu hiệu nhiễm trùng máu đóng vai trò then chốt giúp tăng cơ hội điều trị thành công cho bệnh nhân.
4.1. Bộ tiêu chuẩn qSOFA — sàng lọc nhanh tại cộng đồng
Công cụ qSOFA (quick Sequential Organ Failure Assessment) được sử dụng để sàng lọc nhanh nguy cơ nhiễm trùng huyết ngoài bệnh viện. Nghi ngờ nhiễm trùng huyết khi có từ 2/3 dấu hiệu sau:
| Dấu hiệu | Ngưỡng cảnh báo |
|---|---|
| Thay đổi ý thức | Lú lẫn, mất phương hướng, không nhận ra người thân |
| Thở nhanh | Tần số thở ≥ 22 lần/phút |
| Huyết áp thấp | Huyết áp tâm thu ≤ 100 mmHg |
4.2. Các Dấu Hiệu Cảnh Báo Khác Cần Chú Ý
-
Sốt cao đột ngột trên 38.5°C hoặc hạ thân nhiệt dưới 36°C — nghịch lý nhưng cả hai đều là dấu hiệu sepsis
-
Tim đập nhanh trên 90 lần/phút không rõ nguyên nhân
-
Da nổi vân tím (mottling), lạnh đầu chi, môi và đầu ngón tay tím tái
-
Giảm tiểu đột ngột (dưới 0.5ml/kg/giờ) — dấu hiệu thận đang suy
-
Buồn nôn, nôn, tiêu chảy kèm sốt cao
-
Vết thương nhiễm trùng không cải thiện hoặc nặng hơn nhanh chóng
Nguyên tắc quan trọng: Không cần có đủ tất cả các triệu chứng. Nếu người thân có nhiễm trùng đã biết và bỗng nhiên xấu đi nhanh theo bất kỳ cách nào — đó là dấu hiệu cần cấp cứu ngay.
Hiện tượng da nổi vân tím thường gặp ở bệnh nhân bi nhiễm trùng huyết
5. Ai Có Nguy Cơ Cao Bị Nhiễm Trùng Máu?
Mặc dù nhiễm khuẩn máu có thể xảy ra với bất kỳ ai, các nhóm sau có nguy cơ cao hơn đáng kể:
-
Người cao tuổi trên 65 tuổi — hệ miễn dịch suy yếu, phản ứng viêm không điển hình
-
Trẻ sơ sinh và trẻ nhỏ dưới 1 tuổi — hệ miễn dịch chưa hoàn thiện
-
Người tiểu đường — tăng nguy cơ nhiễm trùng da, đường tiểu và suy giảm chức năng bạch cầu
-
Người suy giảm miễn dịch — HIV/AIDS, đang hoá trị, dùng corticosteroid dài ngày, sau ghép tạng
-
Bệnh nhân nằm viện dài ngày — nguy cơ nhiễm trùng bệnh viện với vi khuẩn kháng thuốc
-
Người có ổ nhiễm trùng mạn tính — loét do nằm lâu, vết thương mãn tính, viêm tuỷ xương
6. Điều Trị Nhiễm Trùng Máu Như Thế Nào?
Sepsis là một tình trạng cấp cứu nội khoa, cần được xử trí nhanh theo “Sepsis Bundle” (gói can thiệp trong 1 giờ) do Surviving Sepsis Campaign khuyến cáo.
Trong vòng 1 giờ đầu:
-
Lấy mẫu cấy máu trước khi dùng kháng sinh
-
Dùng kháng sinh phổ rộng tĩnh mạch ngay lập tức — không chờ kết quả cấy
-
Bù dịch tinh thể 30ml/kg nếu có tụt huyết áp hoặc lactate ≥ 4 mmol/L
-
Đo nồng độ lactate máu để đánh giá mức độ thiếu oxy mô
-
Hỗ trợ hô hấp nếu cần (thở oxy, thở máy)
Điều trị tiếp theo tại ICU:
-
Điều chỉnh kháng sinh theo kết quả cấy máu và kháng sinh đồ
-
Thuốc vận mạch (norepinephrine) nếu sốc nhiễm khuẩn
-
Kiểm soát nguồn nhiễm (dẫn lưu áp xe, phẫu thuật nếu cần)
-
Hỗ trợ thận (lọc máu liên tục — CRRT) nếu suy thận cấp
-
Kiểm soát đường huyết chặt chẽ
Cấy máu giúp phát hiện vi khuẩn (hoặc nấm) đang có trong máu, từ đó xác định nguyên nhân gây nhiễm trùng, đưa ra phác đồ tối ưu và cải thiện tiên lượng
7. Câu Hỏi Thường Gặp
7.1. Nhiễm trùng máu có lây không?
Bản thân sepsis không lây — đây là phản ứng của cơ thể với nhiễm trùng, không phải bệnh truyền nhiễm. Tuy nhiên, vi sinh vật gây ra ổ nhiễm trùng ban đầu (như vi khuẩn MRSA) có thể lây qua tiếp xúc trực tiếp.
7.2. Bệnh nhiễm trùng máu có chữa khỏi được không?
Có — nếu phát hiện sớm và điều trị kịp thời. Tuy nhiên, nhiều người sống sót sau sepsis gặp phải hội chứng hậu sepsis (post-sepsis syndrome) gồm: mệt mỏi mãn tính, rối loạn nhận thức, lo âu, trầm cảm và suy yếu thể chất kéo dài nhiều tháng đến nhiều năm.
7.3. Vết thương nhỏ có thể gây nhiễm trùng máu không?
Có. Dù hiếm gặp ở người khoẻ mạnh, vết thương nhỏ không được vệ sinh đúng cách có thể là cửa ngõ cho vi khuẩn — đặc biệt nguy hiểm với người tiểu đường, người cao tuổi và người suy giảm miễn dịch.
7.4. Nhiễm trùng máu ở người già có nguy hiểm không?
Có. Người cao tuổi là nhóm có nguy cơ cao và dễ diễn tiến nặng hơn do:
-
Hệ miễn dịch suy giảm
-
Thường có bệnh nền (tim mạch, tiểu đường, thận…)
-
Khả năng đáp ứng với nhiễm trùng kém hơn người trẻ
Do đó, nhiễm trùng máu ở người già dễ gây biến chứng nặng, sốc nhiễm trùng và tử vong cao hơn nếu không được điều trị sớm.
7.5. Nhiễm trùng máu bao lâu thì chết?
Không có một mốc thời gian cố định vì diễn tiến của nhiễm trùng máu rất khác nhau ở mỗi người. Trong trường hợp nặng, bệnh có thể tiến triển rất nhanh, chỉ trong vài giờ đến vài ngày nếu không được điều trị kịp thời. Tuy nhiên, nếu được phát hiện sớm và điều trị đúng cách tại bệnh viện, nhiều bệnh nhân có thể hồi phục.
7.6. Làm thế nào để phòng ngừa nhiễm trùng máu?
Không có cách phòng ngừa tuyệt đối, nhưng các biện pháp giảm nguy cơ gồm: tiêm vaccine đầy đủ (cúm, phế cầu, não mô cầu), vệ sinh vết thương kịp thời, điều trị sớm các ổ nhiễm trùng, rửa tay thường xuyên và kiểm soát tốt các bệnh nền như tiểu đường.
Kết Luận
Nhiễm trùng máu (sepsis) là hội chứng đe doạ tính mạng khi hệ miễn dịch phản ứng thái quá với nhiễm trùng, gây tổn thương các cơ quan toàn thân. Với tỷ lệ tử vong 15–50% tuỳ mức độ và hơn 11 triệu ca tử vong mỗi năm trên toàn cầu, đây là một trong những cấp cứu y tế nguy hiểm nhất.
Điều quan trọng nhất cần ghi nhớ: Nhận biết sớm và điều trị trong "giờ vàng" là yếu tố quyết định sự sống còn. Khi thấy người thân có nhiễm trùng đã biết mà bỗng nhiên xấu đi nhanh, lú lẫn, thở nhanh hoặc tụt huyết áp — đừng chờ đợi, hãy gọi 115 ngay lập tức.
Số lần xem: 65